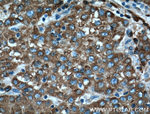
ERp72 Antibody in Immunohistochemistry (Paraffin) (IHC (P))

Search
Proteintech
ERp72 Monoclonal Antibody (1D5F3)
{{$productOrderCtrl.translations['antibody.pdp.commerceCard.promotion.promotions']}}
{{$productOrderCtrl.translations['antibody.pdp.commerceCard.promotion.viewpromo']}}
{{$productOrderCtrl.translations['antibody.pdp.commerceCard.promotion.promocode']}}: {{promo.promoCode}} {{promo.promoTitle}} {{promo.promoDescription}}. {{$productOrderCtrl.translations['antibody.pdp.commerceCard.promotion.learnmore']}}
产品信息
66365-1-IG
种属反应
已发表种属
宿主/亚型
分类
类型
克隆号
抗原
偶联物
形式
浓度
规格
纯化类型
保存液
内含物
保存条件
运输条件
产品详细信息
Immunogen sequence: KQVQEFLKD GDDVIIIGVF KGESDPAYQQ YQDAANNLRE DYKFHHTFST EIAKFLKVSQ GQLVVMQPEK FQSKYEPRSH MMDVQGSTQD SAIKDFVLKY ALPLVGHRKV SNDAKRYTRR PLVVVYYSVD FSFDYRAATQ FWRSKVLEVA KDFPEYTFAI ADEEDYAGEV KDLGLSESGE DVNAAILDES GKKFAMEPEE FDSDTLREFV TAFKKGKLKP VIKSQPVPKN NKGPVKVVVG KTFDSIVMDP KKDVLIEFYA PWCGHCKQLE PVYNSLAKKY KGQKGLVIAK MDATANDVPS DRYKVEGFPT IYFAPSGDKK NPVKFEGGDR DLEHLSKFIE EHATKLSRTK EEL (294-645 aa encoded by BC000425)
靶标信息
ERp72 is an endoplasmic reticulum luminal protein that is both a stress protein and a member of the protein disulfide isomerase family of proteins. Sequence analysis of ERp72 shows that it shares sequence identity with PDI (protein disulphide isomerase) at three discrete regions, as well as containing the ER retention signal KEEL at its C-terminus. ERp72 is shown to have three copies of sequence believed to be CGHC-containing active sites, which are also found in PDI. These CGHC sites are critical sites that are involved in the protein disulphide isomerization process. These results suggest that ERp72 is a newly described member of the family of CGHC-containing proteins that functions as a molecular chaperone.
仅用于科研。不用于诊断过程。未经明确授权不得转售。
生物信息学
蛋白别名: EC 5.3.4.1; Endoplasmic reticulum resident protein 70; Endoplasmic reticulum resident protein 72; ER protein 70; ER protein 72; protein disu; protein disulfide isomerase related protein (calcium-binding protein, intestinal-related); protein disulfide isomerase-associated 4; Protein disulfide-isomerase A4; Protein ERp-72; testicular tissue protein Li 137; unnamed protein product
基因别名: ERp-72; ERP70; ERP72; PDIA4
UniProt ID: (Human) P13667
Entrez Gene ID: (Human) 9601